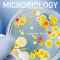

فروش مواد شيميايى آزمايشگاهى
افزودن به پسندها 📞 شماره های تماس 09123665197
02166754850
02166754631
02166754850
02166754631
📞 اطلاعات تماس با آگهی دهنده 

پارس كيميا شيمي (2)
✔️شماره های تماس :: 09123665197 02166754850 02166754631
توضیحات کامل آگهی
پارس كيميا شيمي واردات و فروش مواد شيميايي آزمايشگاهي merck sigmaaldrich با قيمت مناسب وضمانت كالا فروش مواد شيميايي تخصصي زيگما الدريچ و مواد پركاربرد فروش محيط كشت سلولي مرك المان و فلوكا و كيولب ٥٠٠گرمي و ١٠٠گرم فروش معرفها استاندارد ها و تيترازول ارسال فوري به تمامي استانها تلفن تماس ٠٢١٦٦٧٥٤٨٥٠ ٠٢١٦٦٧٥٤٦٣١ ٠٩١٢٣٦٦٥١٩٧
آدرس آگهی :
H _ منطقه هشت تهران, تهران, تهران